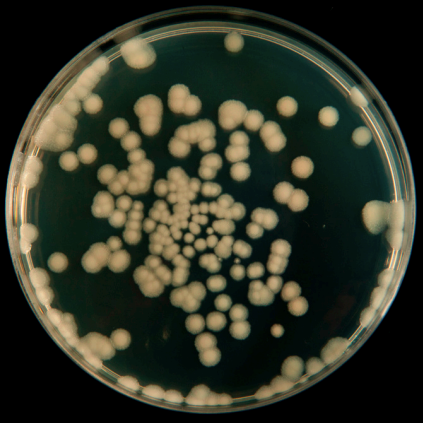
Analizar camarones sanos y observar diferencias entre ellos y los enfermos no significa que los microbiomas de los organismos sanos sean responsables de su salud.

¿Pueden los probióticos paracamarones prevenir ocurar enfermedades?
- sgnewm4
- 19 sept
- 8 Min. de lectura
La mayoría de la gente, cuando oye o emplea el término probiótico, piensa en un yogur con muchas especies microbianas diferentes añadidas. Estos “probióticos” se consumen por vía oral y las bacterias que sobreviven a la barrera de un estómago ácido (que no es la norma en camarones, ya que tienen un intestino con un pH casi neutro) se desplazan por el tracto digestivo, donde colonizan alguna parte del intestino. Se afirma que esto altera el microbioma existente y las bacterias añadidas se convierten en un componente estable del microbioma. Se supone que esto repercute positivamente en la salud del receptor.
Existen mecanismos por medio de los cuales los probióticos podrían, en teoría, curar o prevenir enfermedades. Entre ellos se incluye la competencia por nutrientes esenciales, como cofactores enzimáticos (metales como el Fe o vitaminas), o la producción de antibióticos o péptidos antimicrobianos que inhibirán cepas específicas.
Esta definición tan específica omite la gran cantidad de otras repercusiones que pueden tener las bacterias, desde el impacto en el medio ambiente a través de la biorremediación, hasta la estimulación de la inmunidad no específica en el receptor, etc. También es polémica. El microbioma es un conjunto complejo de múltiples especies de bacterias, hongos y protozoos que colonizan superficies externas e internas. Muchas de las pruebas existentes hasta la fecha sugieren que la adición de “probióticos” puede (o no) causar alteraciones a corto plazo en el microbioma, en el mejor de los casos. La aparente necesidad de dosificar continuamente los probióticos sugiere de manera clara que cualquier alteración del microbioma es temporal.

Muchas bacterias degradan la materia orgánica. Muchas también convierten el amoníaco en metabolitos como nitrito, nitratos y nitrógeno atmosférico. Pueden tener rangos de actividad estrechos u otros rasgos que las hagan poco adecuadas para su uso en productos comerciales para la acuicultura. Algunas son muy buenas, mientras que otras pueden ser extremadamente fastidiosas y otras son poco adecuadas. Algunas empresas ofrecen cepas de Nitrobacter y Nitrosomonas para la nitrificación. Muchas otras bacterias también lo hacen, incluidas varias especies de Bacillus, que pueden secarse, tienen una forma de espora estable en estantería, no requieren refrigeración y no son muy caras. Muchas empresas venden mezclas de bacterias que compiten entre sí, lo que puede reducir la eficacia global del proceso. La variabilidad inherente a los entornos de producción exige que cualquier enfoque estandarizado tenga en cuenta estas variables.
Las paredes celulares de muchos microbios diferentes son capaces de estimular el sistema inmunitario. Esto está bien documentado tanto para peces como para camarones (y mamíferos). En el caso de camarones, el impacto es en gran medida no-específico, ya que no forman anticuerpos, un componente de la respuesta humoral clásica. La naturaleza y la intensidad del impacto dependen de una serie de variables, entre ellas: cantidad de material al que están expuestos, forma, frecuencia de exposición, nivel de estrés de los organismos y funcionamiento de su sistema inmune. Estos factores determinan la intensidad de la reacción inmunitaria.
Muchos estudios de laboratorio se basan en la exposición de organismos en condiciones controladas que no se corresponden con el mundo real. Pueden estar en acuarios o microcosmos con un intercambio de agua limitado, lo que garantiza que ingieran los compuestos repetidamente y a través de múltiples vías. Además, en el caso de las especies de Bacillus formadoras de esporas que germinan y crecen en estos sistemas a niveles suficientemente altos, las células vegetativas son las responsables del impacto observado, no las esporas. Las esporas germinan a velocidades que dependen del entorno y de la cepa.

Los patógenos se dividen en dos categorías generales: son obligados u oportunistas. Muchas bacterias aisladas de organismos enfermos no son la causa de la enfermedad, sino que se aprovechan de su sistema inmunitario debilitado; son oportunistas. Los patógenos obligados pueden causar enfermedades en organismos fuertes y sanos solo con su mera presencia en determinados niveles, proliferar y causar la enfermedad. Los patógenos muy virulentos poseen determinantes de virulencia, propiedades que garantizan que puedan dañar a los organismos sanos. Algunos ejemplos serían las toxinas (como las toxinas PirA y PirB en las cepas de Vibrio parahaemolyticus), enzimas potentes que están presentes en niveles lo suficientemente altos como para dañar los tejidos, y la capacidad para secuestrar nutrientes críticos como el hierro (los vibriones pueden contener genes que codifican para que las proteínas de la membrana externa se unan a estos, haciendo que no estén disponibles para el hospedador).
La mayoría de las veces, las enfermedades agudas de los camarones de piscifactoría son el resultado de múltiples patógenos. Puede tratarse de una mezcla de patógenos oportunistas o de patógenos obligados y oportunistas. En los camarones de piscifactoría, la infección por patógenos como el virus que causa la mancha blanca (WSSV, por sus siglas en inglés) o el agente etiológico fúngico responsable del Enterocytozoon hepatopenaei (EHP) suele ir acompañada de bacteriemias, de las que los vibrios suelen ser un componente principal. Hay muchas otras especies de bacterias que pueden ser problemáticas. La mayoría son oportunistas, pero unas pocas son obligadas.
Puede haber una sinergia entre múltiples patógenos potenciales. El síndrome de las heces blancas en los camarones (un problema común en el sudeste asiático) se debe al hongo EHP y a un vibrio juntos. El EHP por sí solo no causa mortalidad, pero cuando hay coinfección con un vibrio, el resultado son heces blancas y mortalidad aguda. A medida que aumentan los niveles de patógenos en un organismo, este puede conservar su apetito, pero no crecerá, lo que crea una disparidad significativa en los tamaños de la población en la cosecha y altos factores de conversión alimenticia. Su impacto en el hepatopáncreas, órgano crítico para la digestión y la inmunidad, debilita al camarón, haciéndolo muy susceptible a la invasión de patógenos tanto oportunistas como obligados.
Para que los probióticos sean activos mediante la alteración del microbioma y, por tanto, del metaboloma (suma de los metabolitos que produce el microbioma) en la prevención o curación de enfermedades, es necesario considerar varios aspectos. Si previenen enfermedades, tendrían que mantener las cargas de patógenos potenciales por debajo de los niveles umbral que causan enfermedades agudas. Esto, más que probablemente, requeriría que estuvieran presentes de manera constante. La mayoría de las bacterias producen péptidos antimicrobianos y otros compuestos que les permiten competir por los nutrientes a la vez que inhiben a sus competidores.
Existen mecanismos a través de los cuales los probióticos podrían, en teoría, curar o prevenir enfermedades. Entre ellos, competir por nutrientes esenciales, como los cofactores enzimáticos (metales como el Fe o vitaminas) o la producción de antibióticos o péptidos antimicrobianos (AMP, por sus siglas en inglés) que inhibirán cepas específicas. Sin embargo, requieren que una cantidad adecuada de probióticos esté lo suficientemente cerca de los patógenos para ser eficaces. Dado que ningún probiótico comercial persiste en los organismos o en el entorno inmediato a niveles elevados, es poco probable que un probiótico cure o prevenga enfermedades causadas por patógenos obligados mediante la alteración del microbioma.
Estos productos microbianos, como los AMP, no actúan de la misma manera que los antibióticos. Los antibióticos se administran a los organismos en dosis que garantizan niveles tisulares suficientemente altos para inhibir los organismos a los que van dirigidos. No actúan sobre los virus, solo sobre las bacterias y los hongos. Están localizados y los niveles generales en los tejidos no van a funcionar como lo hacen los antibióticos. La observación de que determinadas cepas de bacterias inhiben el crecimiento de otras bacterias por proximidad no significa que esto sea lo que ocurre en el hospedador. Los patógenos suelen estar en biopelículas que los protegen y aíslan, y las cargas tisulares globales son demasiado bajas para actuar como los antibióticos.
El papel del estrés en la susceptibilidad a las enfermedades está bien documentado. Los factores de estrés debilitan a los organismos y los hacen menos capaces de combatir las infecciones. Estos factores incluyen, entre otros, una nutrición inadecuada (exceso o escasez de nutrientes esenciales), densidades excesivamente altas, problemas de calidad del agua (cambios repentinos de salinidad, pH demasiado bajo o demasiado alto, etc.), niveles bajos de oxígeno, niveles altos de metabolitos (H₂S, CH₄, nitrato, nitrito, NH₃/NH₄, etc.), presencia de cepas tóxicas de algas y bacterias, niveles bajos crónicos de patógenos, manipulación frecuente de camarones como resultado de cosechas parciales o traslados, etc.
Los organismos sanos sin estrés están en homeostasis con su entorno. Son capaces de adaptarse a perturbaciones ambientales moderadas sin impactos negativos. Los factores estresantes afectan su capacidad de adaptación y aumentan su susceptibilidad a patógenos obligados y oportunistas.
No hay soluciones mágicas. Los principios básicos influyen en los resultados. No mantener los patógenos obligados fuera de los sistemas de producción aumenta las posibilidades de que los organismos enfermen. El control empieza por los reproductores. El control de patógenos en los camarones de una población no funciona a menos que se trabaje con organismos que hayan sido criados en interiores en condiciones controladas durante al menos varias generaciones y las pruebas repetidas no hayan encontrado nada preocupante. Debe analizarse cada organismo de forma individual. Si bien es posible que niveles bajos de patógenos obligados logren sobrevivir, no es probable que causen problemas en un entorno relativamente libre de estrés en condiciones óptimas. En aras de la precisión, hay patógenos potenciales que deben excluirse por todos los medios, ya que pueden infectar y matar a los organismos cuando están presentes en niveles muy bajos. Por fortuna, son muy poco frecuentes.
El muestreo de la población debe realizarse en nauplios, zoea, mysis y camarones postlarvarios. Las muestras deben ser representativas de la población. Puede ser útil seleccionar camarones manifiestamente enfermos para las pruebas. Los alimentos vivos deben proceder de fuentes totalmente bioseguras y también deben someterse a pruebas exhaustivas. Con demasiada frecuencia, los criaderos usan fuentes locales de poliquetos silvestres o artemias que se producen en masa en condiciones no asépticas, lo que contamina reproductores y, luego, nauplios, zoea, mysis y camarones postlarvarios. Si las pruebas revelan un fallo de bioseguridad, el productor debe comunicar los riesgos a la clientela o destruir el lote y empezar de nuevo con organismos limpios.
El entorno de producción influye en el riesgo. Si los vecinos están muy próximos y no hay salvaguardias que garanticen que no se mezclan afluentes y aguas residuales, aumenta el riesgo de introducir una enfermedad en una población sin inmunidad previa. Muchos han abordado este riesgo mediante el uso generalizado de desinfectantes, normalmente cloro, para tratar el agua entrante antes de la fertilización y la repoblación. Como ya se dijo en un artículo anterior, esto puede empeorar las cosas.
Impulsar los paradigmas de producción para maximizar la productividad muy a menudo tiene como consecuencia el estrés de los camarones. Con demasiada frecuencia, los acuicultores se centran en lo que consideran el balance final: ¿Cuántas toneladas de producto final vendible se pueden producir en un estanque determinado? Lo ideal sería que los productores encontraran el equilibrio entre la búsqueda de la mayor producción posible y la limitación del estrés, que invariablemente es un componente de este planteamiento. Una bioseguridad adecuada y la reducción del estrés son elementos esenciales para un éxito constante.
La desinformación generalizada no ayuda al sector. Incita a la gente a pensar que no debe prestar atención a los aspectos básicos. Al final, puede garantizar que persistan los ciclos de enfermedades graves que afectan la limitar los beneficios y generar nuevos patógenos es una consecuencia directa de enfoques inadecuados. Utilizar todos los medios posibles, por excesivos o inapropiados que sean, para abordar la situación en los estanques no es la mejor manera de hacerlo. Cualquiera con amplia experiencia en la cría de camarones y peces puede dar fe de ello.
Hacer pruebas con organismos sanos y observar diferencias entre ellos y los enfermos no significa que los microbiomas de los camarones sanos sean los responsables de su salud. Incluso cuando se desafían en condiciones controladas, es más que probable que las diferencias observadas se deban a una respuesta inmunitaria no específica.
En última instancia, hay que centrarse en los fundamentos de la bioseguridad y la reducción del estrés. Una vez que se hayan abordado de forma adecuada, los beneficios serán evidentes: mayor supervivencia, mejor crecimiento, mejores índices de conversión y, en definitiva, mayores beneficios.

Comentarios